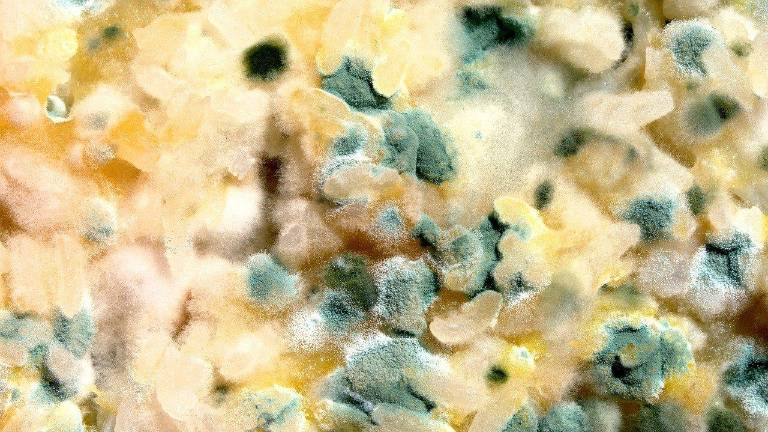

El Consejo Indio de Investigación Médica (ICMR) alertó el pasado domingo de una nueva dolencia que estaba afectando a los sobrevivientes del coronavirus en India. Se trata de la mucormicosis, una infección ocasionada por hongos, que puede llegar a lisiar y ser mortal para las personas. También se la conoce como ‘infección de hongos negros’ y suele aparecer en pacientes con algún tipo de inmunodeficiencia.
Esta enfermedad es causada por la exposición y la inhalación de esperas de moho, hongo que se puede encontrar en el suelo, las plantas, el abono y la comida en descomposición. Tras descubrirse que las personas más vulnerables son aquellas que han estado tomando muchas medicinas recientemente o han pasado un tiempo considerable en unidades de cuidados intensivos, los médicos indios ahora la consideran como una complicación poscovid.
CAUSAS Y SINTOMATOLOGÍA
De acuerdo a los expertos, puede presentarse dolor y enrojecimiento alrededor de los ojos y la nariz, dolor de cabeza, fiebre y tos. También se manifiesta dificultades respiratorias, vómito con sangre y un estado mental alterado. Para los sobrevivientes del covid-19, la murcormicosis puede implicar la pérdida de la mandíbula superior y los ojos.
El doctor especialista en enfermedades infecciosas Atul Patel explicó hoy a Efe que esta infección por hongos, que ya había sido detectada antes de la pandemia tanto en la India como en otros países, afecta sobre todo a "pacientes con una diabetes no controlada o que tienen algunas complicaciones por la diabetes".
"No es algo que todo el mundo pueda contraer", aclaró el doctor, y añadió que, en este sentido, "un factor determinante que también está contribuyendo a aumentar la incidencia es el uso de esteroides para el tratamiento de la infección por la covid-19".
Asimismo, también pueden ser más susceptibles de contraer esta infección las personas que recientemente hayan recibido un trasplante de órganos o hayan permanecido de manera prolongada en la UCI.
Sin embargo, Patel matizó que, pese a que el coronavirus "aumenta la incidencia" de contraer esta infección en un grupo determinado de pacientes porque provoca una bajada en las defensas, no implica que sea el causante directo de esta enfermedad.
De hecho, "la India es el país que reporta el mayor número de mucormicosis cada año", dijo, por lo que insistió en que "es una infección antigua" que se conoce en todo el mundo, y cuya tasa de mortalidad "ronda el 50 %".
PREVENCIÓN
Las autoridades sanitarias de India han expresado su preocupación ya que los niveles de hospitalización de emergencia en ese país, debido al coronavirus, crecen cada día y vuelven a más personas susceptibles a la propagación de los hongos negros. De hecho, los primeros casos de mucormicosis en pacientes con covid fueron reportados en diciembre pasado.
Con más de 300.000 contagios diarios de coronavirus, al personal sanitario de los hospitales se les aconseja monitorear los niveles de glucosa en la sangre de los posibles afectados por el hongo y usar agua perfectamente limpia y estéril en los humificadores que se utilizan en la oxigenoterapia. Además, el IMCR insta a que no se usen en exceso los esteroides (usados para prevenir y tratar alergias), ya que pueden incrementar la expansión de la enfermedad.
Al personal sanitario se le aconseja monitorear los niveles de glucosa en sangre de los posibles afectados, al igual que usar siempre agua perfectamente limpia y estéril en los humidificadores que se utilizan en la oxigenoterapia. El IMCR también insta a un uso no excesivo de esteroides, dado que pueden exacerbar el curso de la enfermedad.
Mientras tanto, a la población general se le ha solicitado que prevenga la inhalación de esporas de moho mediante el uso de mascarillas, zapatos, pantalones y camisas de manga larga (si se trabaja en el campo) así como guantes a la hora de manipular tierra, musgo, estiércol o laborar en obras polvorientas.

.png)
.png)




